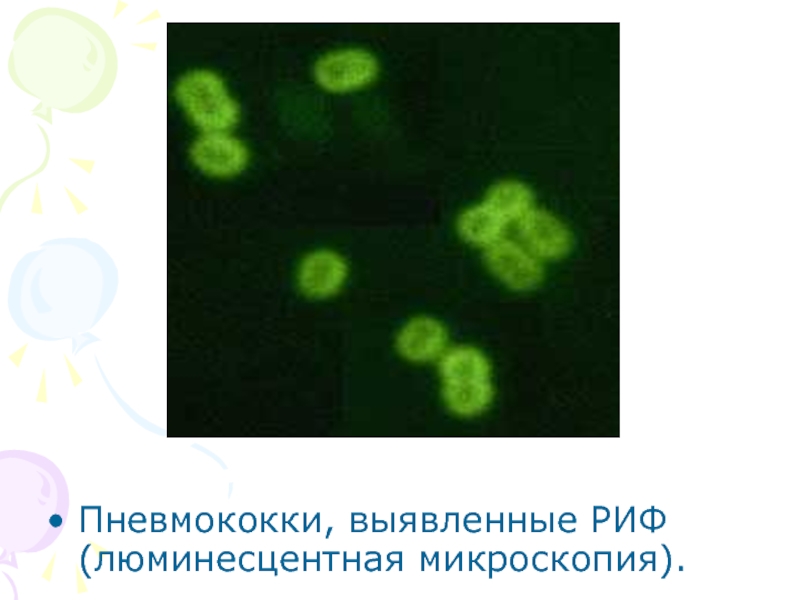

- Главная
- Разное
- Дизайн
- Бизнес и предпринимательство
- Аналитика
- Образование
- Развлечения
- Красота и здоровье
- Финансы
- Государство
- Путешествия
- Спорт
- Недвижимость
- Армия
- Графика
- Культурология
- Еда и кулинария
- Лингвистика
- Английский язык
- Астрономия
- Алгебра
- Биология
- География
- Детские презентации
- Информатика
- История
- Литература
- Маркетинг
- Математика
- Медицина
- Менеджмент
- Музыка
- МХК
- Немецкий язык
- ОБЖ
- Обществознание
- Окружающий мир
- Педагогика
- Русский язык
- Технология
- Физика
- Философия
- Химия
- Шаблоны, картинки для презентаций
- Экология
- Экономика
- Юриспруденция
Иммуно- микробиологические исследования презентация
Содержание
- 1. Иммуно- микробиологические исследования
- 2. Иммунологические методы применяют для решения многих задач:
- 4. Все иммуномикробиологические методы можно разделить на
- 6. Развернутая реакция агглютинации
- 7. Реакция непрямой (пассивной) гемагглютинации (РНГА, РПГА) Схема
- 9. Учет результатов РНГА, поставленной с целью обнаружения ботулотоксина.
- 10. Реакция торможения гемагглютинации (РТГА).
- 11. Типирование вируса проводят в реакции РТГА
- 12. РЕАКЦИИ ПРЕЦИПИТАЦИИ Реакция кольцепреципитации. Реакция преципитации в агаре
- 16. Пневмококки, выявленные РИФ (люминесцентная микроскопия).
- 18. Результат ИФА. Желтый цвет раствора в лунке является положительным результатом.
Слайд 2Иммунологические методы применяют для решения многих задач:
Оценка состояния иммунной системы человека
(иммунного статуса) по определению количественных и функциональных характеристик клеток иммунной системы и их продуктов.
Определение состава и характеристик тканей человека: групп крови, резус фактора, трансплантационных антигенов.
Диагностика инфекционных болезней и резистентности к ним по обнаружению и установлению титров антител (серодиагностика), выявлению антигенов возбудителей в организме, определению клеточных реакций на эти антигены.
. Сероидентификация культур бактерий и вирусов, выделенных из организма человека и животных.
Выявление в организме человека и во внешней среде любых веществ, обладающих антигенными или гаптенными свойствами (гормоны, ферменты, яды, лекарства, наркотики и т.п.).
Выявление иммунопатологических состояний, аллергий, трансплантационных и противоопухолевых реакций.
Определение состава и характеристик тканей человека: групп крови, резус фактора, трансплантационных антигенов.
Диагностика инфекционных болезней и резистентности к ним по обнаружению и установлению титров антител (серодиагностика), выявлению антигенов возбудителей в организме, определению клеточных реакций на эти антигены.
. Сероидентификация культур бактерий и вирусов, выделенных из организма человека и животных.
Выявление в организме человека и во внешней среде любых веществ, обладающих антигенными или гаптенными свойствами (гормоны, ферменты, яды, лекарства, наркотики и т.п.).
Выявление иммунопатологических состояний, аллергий, трансплантационных и противоопухолевых реакций.
Слайд 4
Все иммуномикробиологические методы можно разделить на 3 группы:
основанные на прямом взаимодействии
антигена с антителом (феномены агглютинации, преципитации, гемагглютинации, иммобилизации и др.);
основанные на опосредованном взаимодействии антигена с антителом (реакции непрямой гемагглютинации, коагглютинации, латекс-агглютинации, угольной аггломерации, бентонит-агглютинации, связывания комплемента и др.);
с использованием меченых антител или антигенов (метод флюоресцирующих антител, иммуноферментный и радиоиммунный анализы и другие методы).
основанные на опосредованном взаимодействии антигена с антителом (реакции непрямой гемагглютинации, коагглютинации, латекс-агглютинации, угольной аггломерации, бентонит-агглютинации, связывания комплемента и др.);
с использованием меченых антител или антигенов (метод флюоресцирующих антител, иммуноферментный и радиоиммунный анализы и другие методы).
Слайд 7Реакция непрямой (пассивной) гемагглютинации (РНГА, РПГА)
Схема РПГА: эритроциты (1), нагруженные антигеном
(3), связываются специфическими антителами (4).
Слайд 11Типирование вируса проводят
в реакции РТГА
Условные обозначения: - торможение гемагглютинации
(пуговка) ; - гемагглютинация (зонтик).